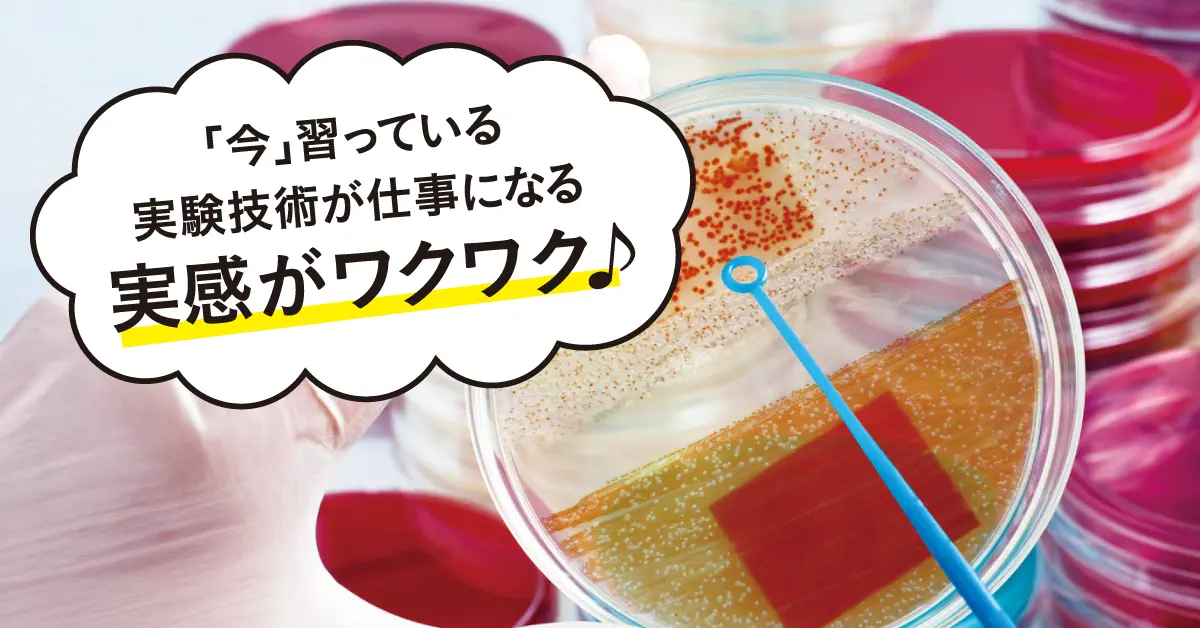
インターンシップ

バイオ・再生医療学科
昼間3年制
バイオサイエンスに関わる分野で求められる基礎技術を、実習中心のカリキュラムで習得。
再生医療・医薬品・化粧品・食品・環境分析・化学など幅広い分野で活躍できるバイオ技術者を育成します。
5つのポイント
-
01POINT01
授業の
60%以上が実習 -
02POINT02
将来どのフィールドに進めばいいか
迷っていても大丈夫!
2年生から選べる4つの専攻 -
03POINT03
国家資格も併せて
9の資格取得を目標 -
04POINT04
インターンシップ
国立大学・公的研究機関などで2ヶ月の
研修が充実 -
05POINT05
正社員で就職率100%
-

医薬品フィールド
遺伝子組換えや細胞培養技術などバイオテクノロジーを用いて医薬品を開発。これまで治療薬がなかったり、従来の医薬品では満足のいく治療が行えなかった病気への効果が期待されています。
-
-

再生医療フィールド
再生医療とは、自分の身体から幹細胞を取り出して培養し、病気や事故などで失われた組織や臓器などを作り出して移植する治療のこと。最近ではiPS細胞を使った再生医療が注目を集めています。
-
-

食品フィールド
微生物の働きを利用して酒、味噌、醤油、納豆、チーズ、ヨーグルトなど発酵食品づくりなどに取り組むほか、近年では遺伝子組み換え作物を 原料に食品の製造を行うなど、食の安全と健康をリードします。
-
-

化粧品フィールド
化粧品原料には化学合成物のほか天然物も用いられます。最近ではバイオ技術によるアンチエイジングなどの働きをもつ機能性化粧品が話題。また、化粧品の開発や品質管理にもバイオ技術は欠かせません。
-
活躍フィールドに関連する主な仕事内容をCheck!
-
研究の仕事

病気の原因を発見したり、肌(化粧品)、健康(食品)に関する有用な成分を見つけ出して効果を調べます。
-
開発の仕事

研究によって発見されたデータに基づき、ニーズに合わせた様々な製品を作り出す仕事です。最も適した成分の組み合わせや配合安全性などを実験によって確かめます。
-
品質管理の仕事

製品の安全を守る仕事です。作られた製品の成分量や形状などが規格に合っているかどうか、使用する人に悪い影響を与えないよう実験によって証明していきます。
-
製造の仕事

研究・開発で提案された処方に従って製造を行います。卓上の実験をスケールアップさせた処方が多いため、しっかりとした実験技術が求められます。
大阪ハイテクノロジー専門学校の
バイオ・再生医療学科の特徴
-

-
大阪ハイテクから広がる
最先端の研究!
3年間にチャンスがいっぱい!!
未来医療の国際拠点
“Nakanoshima Qross”に開設した
滋慶中之島センターで
新しい研究に挑戦!
在学中から再生医療が学べ、細胞培養技術が身につく!
未来医療の国際拠点として2024年6月に誕生した中之島クロスには、日本の再生医療研究や製品開発をリードする病院・企業・研究機関が集結。ここに大阪滋慶学園は「滋慶中之島センター」を開設し、再生医療に関する研究とともに学生の実践教育を展開します。
滋慶中之島センターで実践も!?
-
インターンシップ2年生 夏:2ヶ月間
卒業研究3年生 12月頃まで
-

大学院・企業・研究機関での
インターンシップで
リアルな研究を体験!
-
大阪ハイテクなら業界最先端の研究室でインターンシップを体験でき、入学以来学んできた 知識・技術の確認とともに専門性・実践力を習得できます。
-

-

-
2年生夏の時点で大学院の研究室で通用する実験技術が身についています!!
どんな研究室で?
インターンシップ先には日本を代表する研究室が揃っています。
主な研究室(一例)
どんな研究を?
大阪大学大学院でがんの制御や認知症の研究
関西医科大学大学院でiPS細胞による再生医療の研究 など
資格
9つの資格が取得可能で
就職が有利に!
中級・上級バイオ技術者認定試験
-
バイオ技術に関わる基礎的な知識・技術(遺伝子工学・生化学・微生物学・分子生物学ほか)を判定する資格です
-
中級合格率
90.2%
※過去3年平均
-

-
資格取得に向けた対策授業が充実!
学習到達度に合わせた個別サポートも実施!
さらに!!
上級バイオ技術者認定試験で
成績優秀者!
2020年度上級バイオ技術者認定試験で成績優秀者に選出されました!
※日本バイオ技術教育学会発表
成績優秀者はわずか11名!
専門学校で成績優秀者を輩出しているのは
大阪ハイテクだけ!!
文系出身でも安心!
生物・化学は高校の内容から勉強するので文系出身者でも安心。
また、普段の授業だけでなく資格対策、個別フォローもしっかり対応し、合格に導きます。

-

-
2年生の前期終了までに6つの資格を取得できたことが自信となり、就活にも積極的に取り組めています!
大阪府立門真なみはや高等学校 出身
N.R.さん
資格取得のためのサポートも充実しています
カリキュラム
「目指す将来」を見つけてから
専攻に分かれて専門性を追求するカリキュラム!
基礎から学んで無理なく
ステップアップできる!
基礎科目
1 年生-
講義
生物学・化学・微生物学など、高校の復習を含めた「知識」の基礎固め
-
実習
バイオテクノロジー基礎実習・分析化学実習・生化学実習・微生物学実習などで「実験スキル」の基礎固め
-
実習時間は450時間
専門科目
2 年生-
講義
解剖生理学・免疫学・遺伝子工学・ 細胞工学・品質管理学・化粧品学 など
-
実習
分子生物学実習・細胞培養実習・ バイオ分析演習・医薬品演習・再生医療演習 など
-
免疫学(講義)

ウイルスと戦う免疫を知る!
再生医療や医薬品の働きを知るうえで必要となる免疫機構について基本から学んでいきます。
-
分子生物学実習(実習)

遺伝子を人工的に操作する!
分子生物学的解析における核酸の取り扱い及び分析手法について実習を通して理解していきます。
-
細胞培養実習(実習)

細胞の培養にチャレンジ!
細胞の凍結保存法、初代培養法、継代培養法など、動物の細胞培養に関する基礎技術を習得します。
実習時間は750時間
専攻選択
2 年生2年生前期終了時に、
卒業後に目指す職種にあった専攻を選択!
-
01.再生医療専攻

再生医療に必要な細胞培養やiPS細胞などを扱う高度な実験スキルを習得し、医療業界を目指します。
-
02.医薬品専攻

「くすり」の幅広い知識や実験スキルを身につけ、医薬品やワクチンに関わる業界を目指します。
-
03.コスメ専攻

化粧品(コスメ)成分の効果・効能などの知識と実験スキルを身につけ、化粧品業界を目指します。
-
04.フードサイエンス専攻

食品・環境・化学業界などで必要な実験スキルを習得し、人々の生活を豊かにするバイオ技術者を目指します。
インターン
シップ
2年生後期には
約2ヶ月間の
インターンシップへ!
企業の現場で!大学の研究室で!
- 株式会社ピカソ美化学研究所
- ビューティードア株式会社
- 扶桑薬品工業株式会社
- 株式会社大阪製薬
- 国立循環器病研究センター
- 国立大学法人 大阪大学
- 関西医科大学
※過去実績より一部抜粋
応用学習
3 年生学びの集大成!
業界が求める
バイオ技術者になる!!
-
「就職活動」&「卒業研究」を通して社会に出て
“専門職として働く”ための準備をしていきます。 -

-

-

実習時間は1,080時間
豊富な実習で楽しみながら
実験スキルが身につく!
-

-
\総実習時間は最大2,280時間!/
しかも、一般的な理系大学と比較して実習時間が2倍!
一から技術を身につける時間がたっぷりとあります。
さらに指導する先生は全員業界経験者、または今も現場で活躍中!
時間割例[2年次]
- ※ ★は専攻により選べる演習。基本は2つを選択、希望者は全て選択することも可能!
実習
講義
インターンシップ
固定観念にとらわれない!おもしろい♪
インターンシップで成長!
インターンシップって?
企業に赴き、実習や研修プログラムをもとに就業体験を行う場のこと!自分のやりたいことを見つけたり、業種選びの参考にしたり企業研究を深めることができます。
2年生の夏休み明けから約2ヶ月間インターンシップを体験!
大阪ハイテクなら、企業・大学・大学院などバイオテクノロジー分野の最前線で研修を受けることができます!

-
大阪府立
美原高等学校出身
Mさん業界の「今」をリアルに知る
良い機会となりました。[実習先]
リッツメディカル株式会社
実験技術など学校で今習っていることが仕事になる実感を得られたことが一番大きな収穫でした。卒業後に自分がこの業界で働くイメージがわき、インターンシップ終了後の授業も「確実に将来につながっている」と、さらにモチベーションを高めて学ぶことができています。
実習先も豊富!(過去実績)
- ビューティードア株式会社
- 株式会社大阪製薬
- 泉南乳業株式会社
- 株式会社Q美ワールド
- 株式会社兵庫分析センター
- 株式会社小倉屋 山本
- 静光産業株式会社
- 富士インキ工業株式会社
- 株式会社トランスジェニック
- 日本ステリ株式会社大阪センター
- 扶桑薬品工業株式会社
- ピジョンマニュファクチャリング兵庫株式会社
- 株式会社ミリオナ化粧品 他
就職
卒業後は…ハイテクで身につけた実験技術で
第一専門職に就職率100%
実験技術をもって大学編入することもできる。
高度な実験技術が評価され、
就職率100%
卒業生は
バイオ業界の第一線で活躍中!
-

-
大阪ハイテクは大学と比べて実技系の授業がかなり多く、高度な技術がしっかりと身につくため、先輩たちのようにバイオの最先端企業に就職することができます!
奈良育英高等学校出身
H.Uさん
そのほかの主な就職実績 ※一部紹介
再生医療・医薬品
- 住友ファーマ株式会社
- 協和キリン株式会社
- ニプロ株式会社
- JCRファーマ株式会社
- 扶桑薬品工業株式会社
- 藤本製薬株式会社
- 株式会社JASC
- 共和薬品工業株式会社
- 日新薬品工業株式会社
- 湧永製薬株式会社
- リンパ球バンク株式会社
- 大阪医誠会がん・神経難病治療クリニック
- 神戸ハーバーランド免疫療法クリニック
- 株式会社近畿予防医学研究所 他
化学・化粧品
- 三洋化成工業株式会社
- 株式会社ADEKA
- 倉敷紡績株式会社
- 岩谷瓦斯株式会社
- 新日本理化株式会社
- 昭和化工株式会社
- ナカライテスク株式会社
- 上野製薬株式会社
- 東洋ビューティ株式会社
- 株式会社JTS
- 株式会社成和化成
- 株式会社ピカソ美化学研究所
- 株式会社セブンツーセブン
- 大洋香料株式会社
- 常盤化学工業株式会社
- 株式会社ミリオナ化粧品 他
その他・研究機関・バイオベンチャー
- 国立研究開発法人 医薬基盤・健康・栄養研究所
- 株式会社ケー・エー・シー
- 株式会社トランスジェニック
- 株式会社ホクドー
- 株式会社エーテック 他
食品
- グリコマニュファクチャリングジャパン株式会社
- ミヨシ油脂株式会社
- セッツ株式会社
- 株式会社小倉屋山本
- 株式会社中島大祥堂
- 大松食品株式会社 他
環境・分析
- コベルコ溶接テクノ株式会社
- シミックファーマサイエンス株式会社
- 株式会社アイ・メッツ
- 日本メンテナスエンジニヤリング株式会社
- 株式会社住化分析センター
- 日鉄テクノロジー株式会社
- ユーロフィン分析科学研究所株式会社 他
就職サポートがスゴイ!
1
バイオ企業との強力なコネクション
-
- 卒業生が活躍している企業から、大阪ハイテクだけに寄せられる求人票が多数。
- 2年次の冬には月3社のペースでバイオ企業の採用担当者様が会社説明会を開催。
- 就職決定までの平均受験社数4.1社!(大学生の平均受験社数30.6社 ※マイナビ調べ)
-

2
毎年、全員が早期就職内定!
-
「ナガセ医薬品株式会社」に内定!!
京都府立
亀岡高等学校出身
K.Aさん
創立以来就職率100%
大学編入
卒業後に大学の3年次に編入可能。試験に向けたサポートも万全です。
編入実績
- 大阪市立大学 理学部 地球学科
- 岡山大学 理学部 生物学科
- 愛媛大学 農学部 生物資源学科
- 島根大学 生物 資源科学部 生態環境科学科
- 立命館大学 理工学部 化学科
- 関西大学 工学部 生物工学科
- 京都工芸繊維大学繊維学部 応用生物学科 他